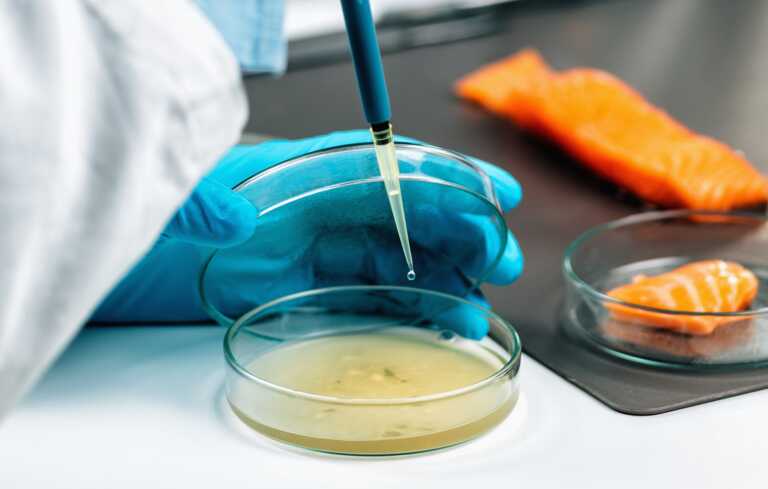

Il 2023 è stato segnato da eventi climatici estremi che hanno colpito duramente l’agricoltura italiana. Tra le calamità, l’alluvione che ha devastato diverse regioni ha causato un calo nella produzione agroalimentare. In questo scenario di difficoltà, c’è una notizia sorprendente: le esportazioni italiane di prodotti agroalimentari sono in aumento e i dati parlano chiaro. Questo fenomeno sottolinea l’importanza crescente per le aziende di dotarsi da un lato delle certificazioni necessarie ad ampliare i mercati per le esportazioni e la GDO, dall’altro della necessità di investire in ricerca e sviluppo. L’export agroalimentare ha mostrato una sorprendente capacità di resilienza e crescita e i mercati internazionali apprezzano qualità e unicità dei prodotti nostrani. Questo successo non è frutto del caso, ma il risultato di un impegno costante verso l’eccellenza e la sicurezza alimentare. Ed è in quest’ottica che si inserisce l’importanza dei sistemi HACCP (Hazard Analysis and Critical Control Points) per identificare e controllare i rischi, delle analisi di laboratorio per il controllo della qualità dei prodotti agroalimentari, per verificare la conformità a standard sanitari e di sicurezza, per rilevare eventuali contaminanti, residui di pesticidi e contraffazioni.
Le certificazioni
In un mercato globale sempre più esigente e competitivo, le certificazioni giocano un ruolo determinante per le aziende che mirano ad ampliare i propri orizzonti e questo comporta l’importanza di acquisire il know-how necessario per ottenerle e mantenerle nel tempo, controllare e gestire i rischi, analizzare i propri prodotti, e investire in formazione sulle normative e le best practice del settore. Diventa fondamentale affidarsi a professionisti specializzati che possano guidarle nel raggiungimento dei più alti standard di qualità. In questo modo, le imprese potranno affrontare con successo le sfide del mercato globale.
I nuovi trend
Le certificazioni agroalimentari sono un insieme di requisiti che vanno ad istituire dei veri e propri standard di sicurezza e qualità. Tra le più rilevanti troviamo le certificazioni biologiche, le DOP (Denominazione di Origine Protetta) e le IGP (Indicazione Geografica Protetta), che attestano l’origine e la genuinità dei prodotti, proteggendoli da imitazioni e contraffazioni. Per esportare in alcuni Paesi è necessario possedere certificazioni quali ad esempio BRC, IFS, FSSC 22000, GlobalGap o certificazioni UNI EN ISO al fine di assicurare prodotti sicuri, conformi alla legislazione e rispondenti a definite specifiche di prodotto o processo. L’attenzione sempre più alta dei consumatori e l’esigenza di poter raggiungere quelli che sono gli obiettivi dell’agenda 2030, fanno si che il mercato si sia spostato su requisiti e certificazioni che mirano ad un concetto di sostenibilità ambientale, sociale ed economica. Ad esempio l’agricoltura biologica che promuove l’uso di metodi naturali, senza pesticidi chimici o fertilizzanti sintetici. Questo riduce l’impatto ambientale e preserva la biodiversità. Le aziende poi stanno adottando misure per evitare sprechi durante la produzione, la distribuzione e la vendita. Si cercano sempre di più fornitori che rispettino standard ambientali e sociali. I consumatori, infine possono fare la loro parte scegliendo prodotti locali, stagionali e a basso impatto. In Italia, ci sono molte iniziative atte a questo scopo, come la certificazione “Made in Italy” e il sostegno alle piccole aziende agricole. Un impegno collettivo che coinvolge produttori, consumatori e istituzioni.